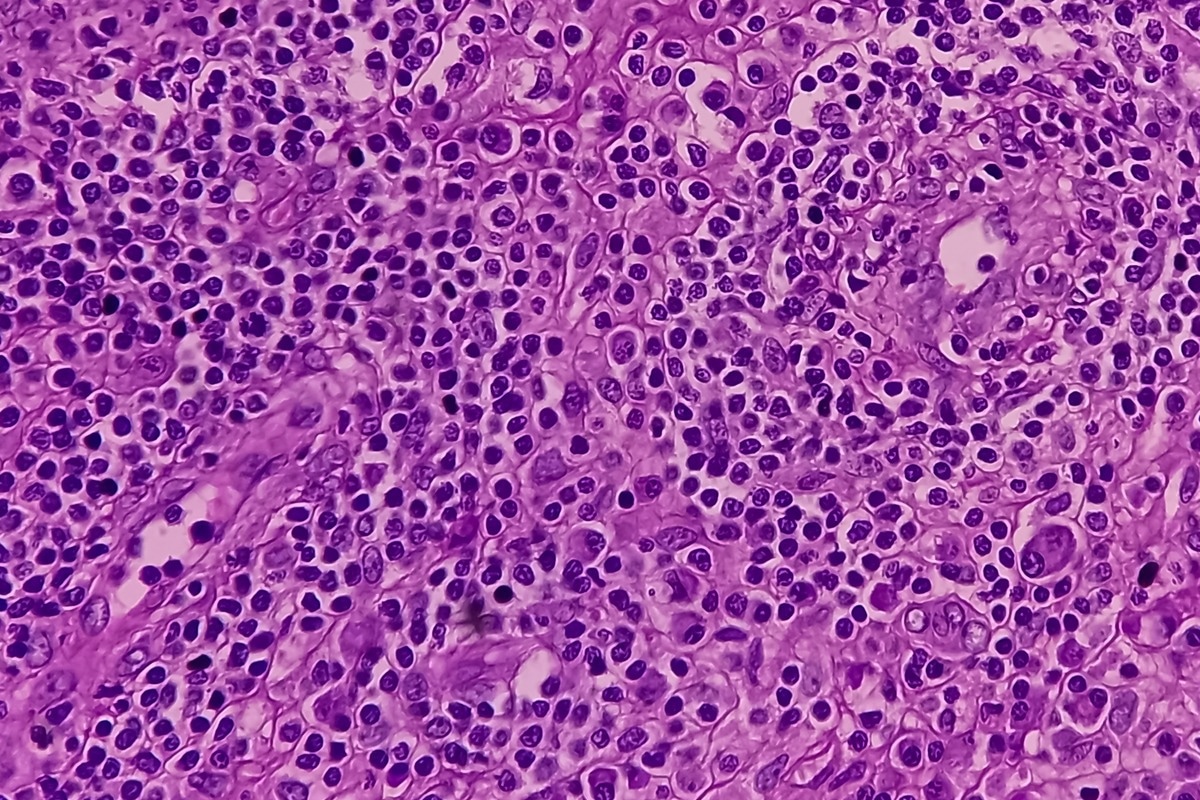
Image Credit: Babul Hosen/Shutterstock

Introduction
Classification
Pathophysiology
References
Further reading
Histiocytic disorders are a group of disorders arising from an over-production of histiocytic white blood cells called histiocytes. ‘Histiocytosis’, meaning ‘tissue cell’, is a general concept for diseases exemplified by myeloid cells, namely mononuclear phagocytes, that share histological features with macrophages or dendritic cells.
Image Credit: Babul Hosen/Shutterstock
Image Credit: Babul Hosen/Shutterstock
Classification
Histiocytic disorders were originally classified by histological features of pathological cells compared with presumed physiological counterparts. There are competing systems for classifying histiocytoses. According to the World Health Organization (WHO), they can be divided into three categories as proposed in the 1999 classification:
- Class I (Histiocytosis-X/Eosinophilic granuloma/ Hand-Schüller-Christian syndrome/ Letterer-Siwe disease)
- Langerhans cell histiocytosis: can be local and asymptomatic, as in isolated bone lesions, or it can involve multiple organs and systems. LCH primarily affects children <10 years of age, Adults are also affected (usually in the third to fifth decades of life). Clinical manifestations and extent of disease established, therefore, depend on the site(s) of the lesions, the organs and systems involved, and their function(s)
- Restrictive LCH: Restricted LCH involves skin lesions without any other site of involvement. Among these, patients may present with solitary lesion (monostotic) lesions with or without diabetes insipidus, adjacent lymph node involvement, or rash.
- Extensive LCH: In polyostotic lesions, patients may present with multiple sites of involvement i.e., several bones are involved or more than two lesions are observed in one bone, with or without diabetes insipidus, adjacent lymph node involvement, or rash. Extensive LHC involves visceral organ involvement with or without bone lesions, diabetes insipidus, adjacent lymph node involvement, and/or rash. In addition, patients may or may not show signs of dysfunction in the liver, hematopoietic system, or lungs. Lesions in the liver spleen and bone marrow are regarded as high risk due to their increased potential for death vs. other low-risk sites.
LCH-associated neurodegeneration (LCH-ND) is a severe complication that can arise with systemic symptoms or several years following an initial LCH diagnosis. LCH-NF shows clinical signs of cerebella dysfunction and abnormal MRI findings in the cerebellum, pons, and brain stem. Positive clinical responses have been demonstrated with chemotherapy and MAPK inhibitors.
- Class II
- Non-Langerhans cell histiocytosis
- Hemophagocytic Lymphohistiocytosis (HLH): this is a syndrome of extreme immune activation. HLH has been divided into primary and secondary forms. The primary form is genetic. Primary HLH is caused by predisposing inherited defects that result from pathogenic variants in genes that form part of inflammasome function, cellular cytotoxicity, and other cellular functions. Secondary HLH arises in the absence of an underlying defect in cytotoxicity. The secondary form of HLH often occurs in association with a strong immunological stimulus – typically infection, malignancy, autoimmune or autoinflammatory conditions. in the absence of prompt immune suppression, young children, as well as adults, are at high risk of death in cases where they present with clinical and laboratory findings that reflect pathological information. For long-term survival in patients with fixed immune defects associated with HLH, allogenic hematopoietic stem cell transplantation is necessary.
- Class III
- Malignant Histiocytic Disorder
Classification of histiocytic disorders is necessary to ensure optimal treatment. While there are dozens of types of histiocytosis, the most common include Class I LCH, and the Class II Erdheim–Chester disease (ECD), juvenile xanthogranuloma (JXG), Rosai–Dorfman disease (RDD; sometimes known as Rosai–Dorfman–Destombes disease) and HLH. The first four diseases demonstrate characteristics of malignant cells, although the implications of oncogenic drivers on classification as ‘cancer’ is a contentious topic.

 Related: Haemophilia Causes
Related: Haemophilia Causes
Pathophysiology
LCH, ECD, JXG, RDD, and HLH are characterized by the accumulation of cells in various tissues. All of these histiocytic disorders co-present with intense inflammatory infiltrate that has a fundamental role in producing organ specific lesions on clinical symptoms. However, the pathological cell may have a different origin and or phenotype in each condition. Although there is overlapping physiology between LCH, JXG, RDD, and ECD, associated with the accumulation of mononuclear phagocytes, the origin of HLH differs significantly, primarily involving activated CD8+ T cells that subsequent drive macrophage activation and extreme systemic inflammation.
Numerous types of histiocytosis have been reviewed in the literature. Overarchingly, they represent a collection of disorders that share a terminal phenotype with features that are congruent with mononuclear phagocytotic cells. LCH, ECD, JXG, and some cases of RDD represent clonal disorders associated with oncogene drivers, which cause aberrant differentiation of myeloid precursors.
Treatment strategies for the variety of these disorders depend on the type of disease and elucidation of optimal therapeutic strategies are often uncertain for most patients. Cytotoxic therapies are often used to cure patients with systemic LCH, ECD, JXG, and RDD - the goal of this is to clear the pathogenic clone.
More recently, MAPK pathway inhibitors are being evaluated for the treatment of subtypes that are driven by MAPK pathways. While many trials have shown high response rates, it has been shown that cessation of MAPK inhibition may result in recurrence. In addition to these two treatment modalities, modulation of the immune system may be used to control inflammation and manage symptoms. Prompt initiation of immune suppression is essential in HLH and hematopoietic stem cell transplantation is necessary when patients present with intractable immune dysfunction.
Histiocytic disorders
References
- McClain KL, Bigenwald C, Collin M. et al. (2021) Histiocytic disorders. Nat Rev Dis Primers. doi: 10.1038/s41572-021-00307-9.
- Emile JF, Abla O, Fraitag S, et al. (2016) Histiocyte Society. Revised classification of histiocytoses and neoplasms of the macrophage-dendritic cell lineages. Blood. doi: 10.1182/blood-2016-01-690636.
- Weiss LM& Facchetti F. in WHO Classification of Tumours of Haematopoietic and Lymphoid Tissues (eds Swerdlow, S. H. et al.) 470–472 (IARC, 2017).
- Vaiselbuh SR, Bryceson YT, Allen CE, et al. (2014) Updates on histiocytic disorders. Pediatr Blood Cancer. doi: 10.1002/pbc.25017. Epub 2014 Mar 9. PMID: 24610771.
Further Reading
Last Updated: Jul 7, 2022